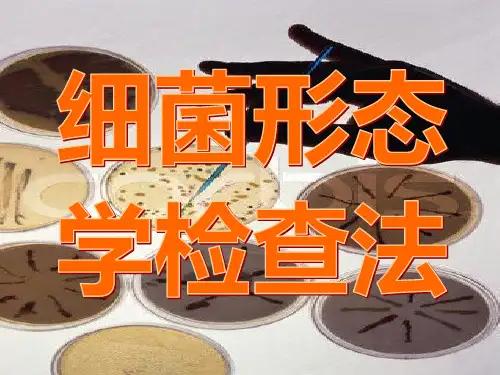

(2)器材和试剂
1、菌种
葡萄球菌 大肠杆菌
2、试剂
初染液 媒染液 脱色液 复染液
革兰染色液
结晶紫 卢戈氏碘液 95%乙醇 稀释石碳酸复红
3、其它
载玻片、染色盘、接种环、酒精灯、生理盐水等
(3)方法与步骤
1、细菌涂片的制备 涂片 干燥
1min
固定
1min
2、染色
初规则
一.进入实验室必须穿护士服,不必需的物品不要 携带入室,严禁在实验室进食、饮水。 二.保持实验室的安静和秩序,实验要严肃认真。 三.如有传染性材料的污染,及时报告老师。 四.实验过程中有仪器和器材的损坏要报告老师 并登记。 五.实验后的材料要放到指定的位置。 六.离开实验室前,要用肥皂洗手,接触过传染性强 的实验材料要用0.1%的新洁尔灭泡手1-2分钟 七.值日生要作好值日工作,关好水,电,门窗,作好 实验记录本的登记方可离开实验室。
2、细菌的形态学观察
革兰染色 (1)原理
革兰阳性菌(G )
+
革兰阴性菌(G )
-
革兰染液: 1、初染液:结晶紫 2、媒染液:卢戈氏碘液 3、脱色剂:95%乙醇 4、复染剂:稀释石炭酸复红
革兰阳性菌细胞壁结构:肽聚糖+磷壁酸
革兰阳性菌细胞壁肽聚糖化学 结构
N-乙酰胞壁酸 N-乙酰葡萄糖胺 四肽侧链 β -1.4糖苷键
生物安全(biosafety)是生物技术安全的总称,指与 生物有关的各种因素对社会、经济、人类健康以及生态环境 所产生的危害或潜在风险。
病原微生物所导致的安全问题,如病原微生物实验室的 安全隐患、生物武器、生化恐怖、重大传染病的爆发流行等, 也是人类所面临的最现实的生物安全问题。
病原微生物实验室生物安全的核心是防扩散和防感染。